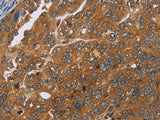
ADAMTS15 Polyclonal Antibody Store at -20°C

ADAMTS15 Polyclonal Antibody Store at -20°C
SKU: E-AB-10171-200
ADAMTS15 Polyclonal Antibody Store at -20°C
| SKU # | E-AB-10171 |
| Reactivity | Human, Mouse |
| Host | Rabbit |
| Applications | IHC |
Product Details
| Isotype | IgG |
| Host | Rabbit |
| Reactivity | Human, Mouse |
| Applications | IHC |
| Clonality | Polyclonal |
| Immunogen | Recombinant protein of human ADAMTS15 |
| Abbre | ADAMTS15 |
| Synonyms | A disintegrin and metalloproteinase with thrombospondin motifs 15, A disintegrin like and metalloprotease reprolysin type with thrombospondin type 1 motif 15, A disintegrin like and metalloprotease reprolysin type with thrombospondin type 1 motif 15 preprop |
| Swissprot | |
| Cellular Localization | Secreted>extracellular space>extracellular matrix. |
| Concentration | 0.6 mg/mL |
| Buffer | Phosphate buffered solution, pH 7.4, containing 0.05% stabilizer and 50% glycerol. |
| Purification Method | Affinity purification |
| Research Areas | Cancer, Signal Transduction |
| Conjugation | Unconjugated |
| Storage | Store at -20°C Valid for 12 months. Avoid freeze / thaw cycles. |
| Shipping | The product is shipped with ice pack,upon receipt,store it immediately at the temperature recommended. |
Related Reagents
| Applications | Recommended Dilution |
| IHC | 1:50-1:200 |
Background
This gene encodes a member of the ADAMTS (a disintegrin and metalloproteinase with thrombospondin motifs) protein family. ADAMTS family members share several distinct protein modules, including a propeptide region, a metalloproteinase domain, a disintegrin-like domain, and a thrombospondin type 1 (TS) motif. Individual members of this family differ in the number of C-terminal TS motifs, and some have unique C-terminal domains. The protein encoded by this gene has a high sequence similarity to the proteins encoded by ADAMTS1 and ADAMTS8.